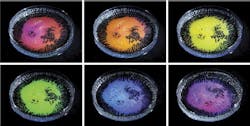

"Structural color" explains iridescence from clear water droplets
In a Nature paper, a team of researchers at Penn State (University Park, PA) and the Massachusetts Institute of Technology (MIT; Cambridge, MA) describe how a surface covered in a fine mist of transparent droplets and lit with a single white light lamp can produce bright, iridescent colors if each tiny droplet is precisely the same size. This newly explained form of "structural color" could aid in the development of brilliantly colored cosmetics, color-changing paints, or adaptive camouflage.
"The typical way you get color is with dyes or pigments, which have molecules that selectively absorb and scatter specific wavelengths of light," said Lauren Zarzar, assistant professor of chemistry at Penn State and a leader of the research team. "Structural color is different. It's a product of light interacting with a material in a way that causes light interference. Structural color is often iridescent and the color we see depends on the angle we are looking from and the angle of the light. We see it in things like opals, butterfly wings, beetles, and bird feathers."
The team first noticed the phenomenon while studying transparent droplet emulsions made from a mixture of oils of different density and water-based surfactants—compounds that reduce surface tension in liquids and are used in soaps and detergents. They were observing the droplets' interactions in a clear Petri dish, when they noticed the drops appeared surprisingly colorful, and the colors changed with viewing direction.
"We didn't set out to discover this," said Amy Goodling, a graduate student in materials science and engineering at Penn State and co-first author of the paper. "We have been working with these droplets for a while because the combination of oils and surfactants create droplets with a particular internal structure. It wasn't until we started making droplets that were uniform in size that the color became noticeable."
"Initially we followed the effect that causes rainbows," said Sara Nagelberg, a graduate student at MIT who headed up the modeling effort to try to explain the effect. "But it turned out to be something quite different."
The droplets that produced color are not perfect spheres like those that form rainbows. Instead, both droplets of water that condense on a surface and the internal structure of the specialized oil and surfactant droplets have a hemispheric—or dome-like—shape. Light behaves differently in hemispheres than it does in spheres. Specifically, the curve of the hemisphere and the sharp change in refractive index between the inside of the hemisphere and outside of it allows an optical effect that is not possible in perfect spheres: total internal reflection.
Once light makes its way into one of the hemispherical droplets, the researchers found that it can take different paths, bouncing two, three, or more times before exiting at another angle. The way light rays that have taken different paths through the droplet add up and interfere with each other as they exit determines whether a droplet will produce color or not.
The researchers developed a model that predicts the color a droplet will produce, given specific structural and optical conditions, such as the size and curvature of the droplets, along with the droplet's total internal reflection. Nagelberg and Kolle incorporated all these parameters into a mathematical model to predict the colors that droplets would produce. Zarzar and Goodling then tested the model's predictions against actual droplets they produced in the lab. The model could be used as a design guide to produce, for example, droplet-based litmus tests, or color-changing powders and inks in makeup products, paints, or displays.
Because synthetic dyes can be hazardous and are strongly regulated, companies are asking whether structural colors can replace potentially unhealthy dyes. Droplets with precisely controlled sizes lit from a single light source produce brilliant colors that shift from blue to green and yellow and red as you move around them. Changing the size and shape of the droplets changes the colors they produce.
In addition to liquid droplets, the researchers 3D-printed tiny, solid caps and domes from various transparent, polymer-based materials, and observed a similar colorful effect in these solid particles, that could be predicted by the team's model. The research team expects that the model may be used to design droplets and particles for an array of color-changing applications.
SOURCE: Penn State; http://science.psu.edu/news-and-events/2019-news/Zarzar2-2019
About the Author

Gail Overton
Senior Editor (2004-2020)
Gail has more than 30 years of engineering, marketing, product management, and editorial experience in the photonics and optical communications industry. Before joining the staff at Laser Focus World in 2004, she held many product management and product marketing roles in the fiber-optics industry, most notably at Hughes (El Segundo, CA), GTE Labs (Waltham, MA), Corning (Corning, NY), Photon Kinetics (Beaverton, OR), and Newport Corporation (Irvine, CA). During her marketing career, Gail published articles in WDM Solutions and Sensors magazine and traveled internationally to conduct product and sales training. Gail received her BS degree in physics, with an emphasis in optics, from San Diego State University in San Diego, CA in May 1986.